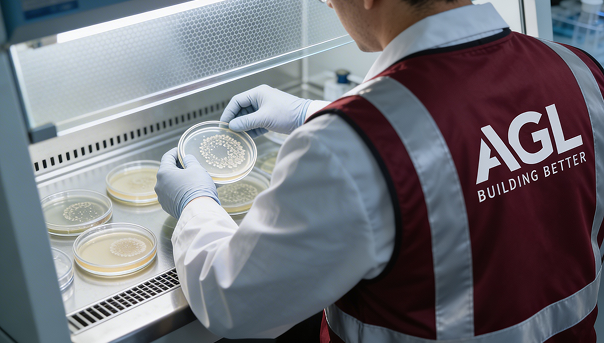

Testing
Accurate engineering data for compliance and performance.
Reliable Engineering Data for Design, Compliance & Performance
We provide laboratory and field testing to validate ground conditions, material properties, environmental safety, and system performance.
Geotechnical Investigation
Understanding the ground before you build.
Soil investigation & boreholes
Bearing capacity & settlement analysis
Laboratory & in-situ soil testing
Geotechnical reporting & foundation recommenda
Geophysical Surveys
Seeing beneath the surface — without excavation.
MASW & seismic surveys
GPR scanning
Electrical resistivity tomography
Void & weak zone detection
Construction Materials Testing
Confirming materials meet design expectations.
Land & Hydrographic Survey
Precise measurement supporting accurate construction.
Topographic & cadastral surveys
As-built verification
Utility detection & mapping
Marine & bathymetric surveys
Environmental, Chemical & Microbiological Testing
Precise measurement supporting accurate construction.
MEP Testing & Commissioning
Verifying systems before operation.
HVAC balancing
Electrical & substations
Plumbing & drainage
Leak detection & CCTV inspection
Aluminium & Glass Testing
Building envelope performance validation.